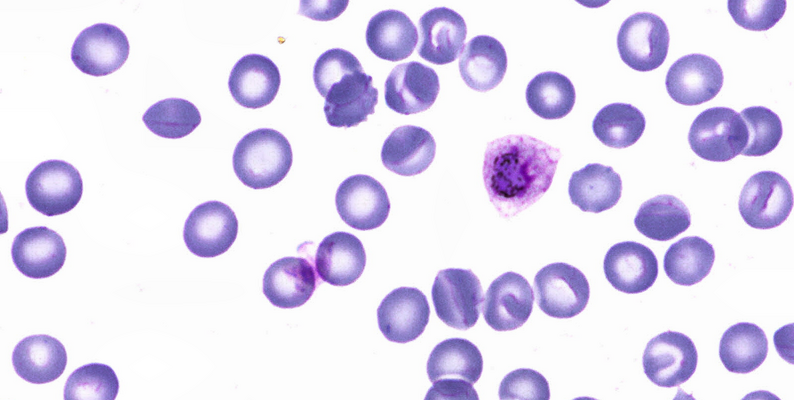

🧑 博主简介:曾任某智慧城市类企业
算法总监,目前在美国市场的物流公司从事高级算法工程师一职,深耕人工智能领域,精通python数据挖掘、可视化、机器学习等,发表过AI相关的专利并多次在AI类比赛中获奖。CSDN人工智能领域的优质创作者,提供AI相关的技术咨询、项目开发和个性化解决方案等服务,如有需要请站内私信或者联系任意文章底部的的VX名片(ID:xf982831907)
💬 博主粉丝群介绍:① 群内初中生、高中生、本科生、研究生、博士生遍布,可互相学习,交流困惑。② 热榜top10的常客也在群里,也有数不清的万粉大佬,可以交流写作技巧,上榜经验,涨粉秘籍。③ 群内也有职场精英,大厂大佬,可交流技术、面试、找工作的经验。④ 进群免费赠送写作秘籍一份,助你由写作小白晋升为创作大佬。⑤ 进群赠送CSDN评论防封脚本,送真活跃粉丝,助你提升文章热度。有兴趣的加文末联系方式,备注自己的CSDN昵称,拉你进群,互相学习共同进步。

【CV数据集介绍-07】疟疾检测数据集:助力医学影像分析与疟疾诊断的宝贵资源
- 一、引言
- 二、数据集概览
- 三、数据集的应用价值
一、引言
疟疾,作为一种由疟原虫引起的全球性健康威胁,影响着数以百万计的人口。而疟疾的检测和诊断一直是医学影像分析领域的关键挑战之一。近年来,随着人工智能技术的飞速发展,自动化疟疾检测和细胞分类模型逐渐崭露头角,成为提高疟疾诊断效率和准确性的有力工具。
今天,我为大家介绍一个名为 P. Vivax (疟疾) 感染人类血涂片数据集 的宝贵资源,它为从事疟疾检测和医学影像分析的研究人员提供了一个强大的工具。
二、数据集概览
P. Vivax (疟疾) 感染人类血涂片数据集 是一个专为疟疾检测任务而设计的数据集,由麻省理工学院Broad研究所发布。它包含了来自巴西马拉尼昂州的马瑙斯和泰国的 1328 张 P. Vivax 感染患者的血涂片图像,这些图像使用吉姆萨染色剂进行染色,以便疟疾研究人员能够清晰地观察和识别受感染的细胞及其阶段。

该数据集共标注了 86035 个对象,涵盖 7 个不同的类别,具体如下:
- 红细胞(Red Blood Cell) :数量最多,共 83034 张图片。红细胞是血液中数量最多的细胞,疟原虫主要寄生于红细胞内,检测受感染红细胞对于疟疾诊断至关重要。
- 滋养体(Trophozoite) :包含 1584 张图片。滋养体是疟原虫在红细胞内发育的一个阶段,此阶段疟原虫会摄取红细胞内的血红蛋白,为自身生长提供营养。
- 环状体(Ring) :有 522 张图片。环状体是疟原虫侵入红细胞后的早期形态,因其在显微镜下呈现环状而得名,是疟疾早期诊断的重要标志之一。
- 困难分类细胞(Difficult) :共 446 张图片。当细胞的分类不明确,无法清晰划归为某一特定细胞类别时,便被标注为困难分类细胞。这些细胞的存在增加了数据集的复杂性,也更贴近实际检测中可能遇到的各种情况。
- 裂殖体(Schizont) :包含 190 张图片。裂殖体是疟原虫在红细胞内发育的成熟阶段,能够进行无性繁殖,产生多个裂殖子,裂殖子释放后会侵入新的红细胞,导致疟疾的进一步发展。
- 配子体(Gametocyte) :包含 156 张图片。配子体是疟原虫的有性阶段,当蚊子叮咬人体时,配子体可被蚊子摄取并在蚊子体内发育为配子,进而完成疟原虫的生命周期,是疟疾传播的关键环节之一。
- 白细胞(Leukocyte) :数量为 103 张图片。白细胞在疟疾检测中虽然不是主要的感染目标,但它们的存在对于血涂片的整体分析和诊断具有一定的参考价值。


数据集被分为训练集和测试集两个子集,训练集包含 1208 张图像,用于模型的训练和优化;测试集包含 120 张图像,用于对训练好的模型进行评估和验证。整个数据集的大小约为 2GB,方便研究人员下载和使用,预测的结果图。


三、数据集的应用价值
这个数据集主要应用于疟疾检测中的目标检测任务,助力医学影像分析。研究人员可以利用这些带有边界框标注的图像,训练自动化的细胞分类模型,以提高疟疾诊断的速度和准确性。借助该数据集,研究人员能够开发出更高效、更可靠的疟疾检测算法,从而在实际应用中减少人为误差,提升疟疾诊断的效率,为疟疾的防治工作提供有力支持。
如果您在疟疾检测、医学影像分析或相关领域开展研究,不妨下载并使用这个数据集。希望它能够助力您的研究取得突破性的成果,为全球疟疾防治事业贡献一份力量。
注: 博主目前收集了6900+份相关数据集,有想要的可以领取部分数据:




























 被折叠的 条评论
为什么被折叠?
被折叠的 条评论
为什么被折叠?










